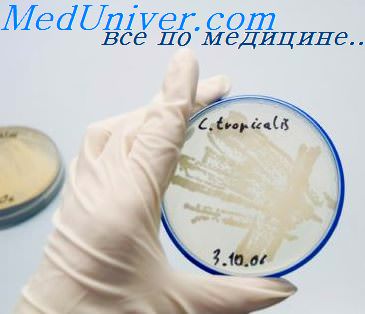

Среди многих людей бытует ошибочное мнение, что кандидоз является сугубо женским заболеванием. Это в корне неверно. При тесном контакте с зараженной женщиной в организм мужчины может легко попасть возбудитель инфекции – дрожжеподобные грибки, относящиеся к роду Кандида. Вначале они закрепляются на поверхности слизистой. Затем наблюдается процесс развития и пускания спор, а далее – постепенно поражаются внутренние органы. Интересно, что представители сильного пола могут являться лишь носителями данного заболевания при отсутствии каких-либо выраженных симптомов.
Важно! Наиболее подвержены заражению молочницей мужчины, которые:
- имеют пагубные привычки;
- являются сверхчувствительными к неблагоприятной экологической обстановке;
- подвергаются частым стрессам;
- страдают хроническими заболеваниями;
- принимают определенные антибактериальные препараты в течение длительного времени;
- имеют ослабленный иммунитет.
Как проявляется молочница у мужчин можете узнать тут>>
Может ли мужчина заразиться молочницей от женщины?
Может. Инфицирование молочницей может произойти при следующих обстоятельствах:
- в процессе незащищенного полового акта, в том числе анального;
- через поцелуй;
- во время оральных ласк.
Медики не накладывают запрета на сексуальные отношения на период лечения, но рекомендуют, все же, воздерживаться. После завершения медикаментозного курса интимная близость может быть восстановлена в полном объеме, если анализы показали излечение обоих партнеров.
- Механизм развития
Дрожжевые грибки, в большом количестве населяющие слизистые поверхности женских половых органов или кишечника, попадают на кожу полового члена. Если крепкий иммунитет, организм с заболеванием справится самостоятельно, не допустив размножения грибка. Но, если имеют место предрасполагающие факторы, возбудитель инфекции закрепляется на головке полового члена и/или внутреннем листке крайней плоти, начиная активно делиться.
- Инкубационный период
Первые проявления молочницы, поразившей половые органы или прямую кишку, появляются спустя 4-5 суток после инфицирования. Иногда инкубационный период заболевания может быть увеличен до 10 суток.
- Первичные симптомы
Появляется раздражение и сильный зуд в области паха и половых органов. Возможны незначительные высыпания в указанных местах и ощущение жжения. Состояние часто сопровождается затрудненным и болезненным процессом мочеиспускания. Иногда присутствует дискомфорт при половом акте.
- Как избежать передачи?
Вариантов обезопасить организм от инфицирования молочницей немного, вернее, один. Во время интимной близости с зараженной женщиной нужно использовать презерватив. Если мужчина состоит в отношениях с постоянной партнершей (женой), специалисты рекомендуют пройти обоим партнером одновременное лечение.
Может.
- Механизм развития
Передача молочницы через поцелуй происходит в редких случаях. Данный процесс обусловлен наличием грибковых поражений слизистой ротовой полости партнерши. Слюна практически не играет никакой роли, в ней количество возбудителя незначительно. Инфекция попадает на слизистую поверхность полости рта мужчины, затем – проникает в клетки, начиная продуцировать определенные ферментативные вещества. Как и в случае с заражением через половой акт, патогенная микрофлора может не закрепиться на слизистой рта, соответственно, не начать размножаться, если иммунная система не ослаблена.
- Инкубационный период
До появления первых отчетливых проявлений кандидоза в ротовой полости проходит 7-10 суток.
- Первичные симптомы
- Сухость во рту.
- Раздражение, отечность, покраснение слизистой рта.
- Болезненность при разговоре и приеме пищи.
Далее на слизистой поверхности рта появляются крупинки белого цвета, который впоследствии объединяются в конгломераты, образуя сплошную поверхность, состоящую из плотного творожистого налета.
- Как избежать?
Предотвратить инфицирование через поцелуй довольно сложно. Ведь мужчина может не знать, что женщина больна кандидозом. Кстати, она и сама может быть не в курсе наличия у себя данного заболевания. Медики в этом случае дают единственный совет: избирательно относиться к выбору партнерш для поцелуев и интимных отношений.
Можно ли заниматься интимной жизнью при молочнице? Подробный ответ>>
Да, молочница передается партнеру.
- Механизм развития
Источником инфекции в данной ситуации выступает пораженная кандидозом слизистая рта женщины. Патогенные микроорганизмы попадают на поверхность полового члена. Если иммунная система в силах подавить инфекцию, заражения не произойдет. Если она ослаблена – инфицирование, скорее всего, наступит.
- Инкубационный период
Развитие болезни протекает поэтапно. До появления первых ее признаков проходит традиционный срок – от 5 до 10 суток. Чем слабее иммунитет, тем быстрее и отчетливее проявится кандидоз.
- Первичные симптомы
Характерные признаки идентичны с проявлениями, которые имеют место после инфицирования молочницей через половой акт с зараженной женщиной. Это зуд, жжение, рези в области паха, мочеиспускательного канала и половых органов, высыпания различного генеза. Дискомфорт в пояснице и нижней части живота. Немного позднее на поверхности крайней плоти и головке полового члена возникает белесый налет творожистой консистенции.
Не заниматься с инфицированной женщиной оральным сексом без использования презерватива. Ну и, конечно, тщательно подходить к вопросу о выборе партнерши для интимной близости.
Чтобы свести вероятность заражения кандидозом от женщины к минимуму, независимо от способа передачи возбудителя инфекции, нужно регулярно прибегать к профилактическим мерам, способствующим повышению иммунитета. Также следует избавиться от пагубных привычек, быть осмотрительным в выборе сексуальных партнерш и вести здоровый образ жизни в целом. Уважаемые мужчины, будьте здоровы!
Молочница или вагинальный кандидоз — одно из самых распространенных заболеваний среди женщин, но многие из них стесняются спрашивать о ней даже у гинеколога. Обильные белые творожистые выделения, болезненность во время мочеиспускания, зуд и жжение в паху, неприятные ощущения во время секса — все это признаки молочницы.
Всем известно, что молочница — заразное заболевание. Ее возбудитель — грибок Кандида, который передается от человека к человеку различными путями, в том числе и половым. Поэтому чтобы кандидозом не заболел мужчина, во время сексуального контакта с партнершей больной молочницей, рекомендуют использовать презерватив. И тут возникает резонный вопрос: «А может ли мужчина заразить женщину молочницей?».
Миллионы ревнивых жен, измученные регулярно появляющимися симптомами молочницы, хотели бы получить конкретный ответ на этот вопрос и наконец-то поставить точку отношениям с мужчиной, которого они подозревают в заражении. Однако даже самые известные ученые всего мира до сих пор не могут прийти к однозначному ответу на этот вопрос и твердо заявить: «Да, молочница к женщине возвращается снова и снова потому, что ей изменяет партнер».
Если женщина задаст этот волнующий ее вопрос своему гинекологу, то, скорее всего, его ответ будет таким: «Молочница не является венерическим заболеванием. Она любит возвращаться, как бумеранг, только тем женщинам, у которых слабый иммунитет или имеются нарушения кислотно-щелочного баланса влагалища».
Передача грибков Кандида от мужчины к женщине осуществляется не всегда. Нельзя с полной уверенностью утверждать, что мужчина обязательно заражен, если он занимался сексом с инфицированной женщиной. Патогенные микроорганизмы попадают на половые органы при контакте, однако они не размножаются у здоровых мужчин с сильным иммунитетом, соблюдающих гигиену половых органов.
А вот у женщин значительно выше риск инфицирования, так как женские половые органы имеют складки, где созданы оптимальная влажность и тепло, способствующие быстрому размножению патогенных микроорганизмов. Согласно статистике, в 4-х из 10-ти случаев передача молочницы происходит половым путем. Это значит, в остальных 6-ти случаях причиной возникновения кандидоза является не секс с инфицированным мужчиной, а общее ослабление организма из-за перенесенных заболеваний, стрессов, диеты, недосыпаний, гормональных изменений в организме и нарушения обмена веществ.
Гинекологи уверены, что возвращается молочница вновь и вновь обычно тем женщинам, которые психически настроены на болезнь. Ведь женщина, которая постоянно подозревает мужа и требует у него объяснения, почему зуд и жжение во влагалище проходят после лечения, а при половом контакте с ним возобновляются опять с новой силой, всегда находится в нервном напряжении.
На самом деле, объяснить причину регулярных рецидивов молочницы просто. Часто у мужчин нет выраженных клинических симптомов молочницы, но при этом они являются носителями заболевания. Поэтому лечиться от молочницы надо вдвоем, а не только женщине. Ей надо применять лекарства в виде свечей, а ему подойдёт крем, или оба партнёра могут использовать таблетки.

Многие современные противогрибковые средства помогают избавиться от неприятных симптомов молочницы уже на второй день с начала лечения, но это не значит, что дальше можно не применять свечи, крема, гели и таблетки. Если не закончить лечение, молочница может вернуться. Полное лечение молочницы занимает около 7 дней, в запущенных случаях — две недели. Чем быстрее начата терапия, тем легче избавиться от молочницы. Откладывать лечение нельзя: запущенная инфекция нередко приводит к уретриту, циститу или цервициту.
В клинической практике врача заражение кандидозом от полового партнера не считается главным фактором. Дрожжеподобные грибы Кандида являются представителями нормальной микрофлоры и встречаются они даже у совершенно здоровых людей. Как правило, их много в кишечнике. Именно из него они расселяются по всему организму.
Но кандидоз не развивается беспричинно. Если молочница часто возвращается, то это серьезный повод задуматься о своем здоровье. Может, у вас есть скрытое хроническое заболевание или ваш уровень жизни далёк от здоровой. Попробуйте, избавиться от лишних килограммов, откажитесь от вредных привычек, начните правильно питаться и больше двигайтесь. Занявшись улучшением качества своей жизни, можно повысить иммунитет и навсегда избавиться от молочницы.
Обратите внимание, если молочница повторно появляется сразу после менструации, то причиной этого может быть пользование тампонами. Женщинам, часто болеющим молочницей, лучше во время менструации использовать прокладки, а не тампоны. Прокладки следует менять через каждые 4 часа и не забывать при этом каждый раз подмываться, используя специальные средства для интимной гигиены.
— Вернуться в оглавление раздела «Гинекология»
Многие мужчины считают, что молочница – это исключительно женское заболевание, и при проявлениях у партнерши таких симптомов должна лечиться только она. Часто ведутся споры, может ли мужчина заболеть этой грибковой патологией и, как следствие, может ли быть мужчина переносчиком молочницы.
Известно, что у женщин часто диагностируют молочницу в латентной и обостренной стадии. Женщина является при этом переносчиком болезни. Именно по этой причине мужчина может заразиться грибковым заболеванием при половом контакте. Риск заражения от партнера резко возрастает, если у здорового человека в это время снижен иммунитет.
Причины мужской молочницы
Молочница у мужчин может быть вызвана как внешними, так и внутренними факторами. При этом происходит нарушение микрофлоры половых органов. Бактерии, которые сдерживают размножение патогенных микроорганизмов, слабнут и гибнут. Патогенные свойства грибка под названием Кандида активизируются во время его активного роста и провоцируют воспалительный процесс на стенках влагалища у женщин и на головке полового члена у мужчин.
Как правило, развитию молочницы способствуют такие факторы:
- нарушение работы иммунной системы;
- хронические болезни, в том числе инфекционные;
- использование некачественных средств для интимной гигиены;
- болезни, передающиеся при половом акте;
- воспаление в мочеполовой системе;
- заболевания женских половых органов (яичники, маточные трубы и матка);
- кишечный дисбактериоз;
- длительное употребление антибиотических препаратов, гормональных и противозачаточных средств;
- нарушения в функционировании эндокринной системы;
- гормональные сбои;
- иммунодефицит;
- хроническая усталость и стрессы.
Мужчина может заразиться молочницей от женщины в период, когда кандидоз находится в стадии обострения. При этом она является переносчиком инфекции. Заразить молочницей партнера возможно при половом контакте без презерватива. Длительное время заболевание может никак не проявляться, и мужчина будет жить активной половой жизнью, уже будучи инфицированным.
Если женщина, страдающая острой стадией молочницы, будет иметь беспорядочные половые контакты, практически во всех случаях все ее партнеры будут заражены. Исходя из этого, доктора при выявлении молочницы у женского пола настоятельно рекомендуют проходить лечение обоим партнерам.
Чтобы у парня возник кандидозный баланопостит, одного инфицирования грибком недостаточно. Патология прогрессирует при травмировании головки полового члена или при наличии серьезных метаболических нарушений в организме, а также при сниженном иммунитете. Часто провоцирующим фактором становится сахарный диабет. Симптоматика молочницы у мужчин следующая:
- отекает и краснеет головка полового органа;
- на дерме головки возникает мелкая сыпь, которая через время превращается в пузырьки;
- далее развивается эрозия;
- из члена начинаются выделения;
- половой член, в особенности головка, зудит;
- во время полового акта ощущается болезненность.
Также заражение происходит и при оральном сексе. В таких случаях кандидоз может поразить слизистую оболочку полости рта и проникнуть в пищеварительный тракт, поражая микрофлору кишечника. К другим причинам, когда у мужчины возникает данная патология, кроме инфицирования через половой контакт, относят:
- хронические патологии в работе пищеварительных органов;
- СПИД;
- иммунодефицитные состояния;
- туберкулез;
- чрезмерное употребление алкоголя и табачных изделий;
- прием наркотических веществ;
- избыточный вес;
- продолжительные стрессы;
- депрессивные состояния;
- частую смену половых партнеров.
Грибки, относящиеся к роду Кандида, присутствуют в человеческом организме на протяжении всей жизни, не причиняя никакого дискомфорта. Узнать о наличии грибка можно лишь при определенных условиях. В ситуациях, когда иммунная система дает сбой, патогенные микроорганизмы активизируются, убивая при этом полезные бактерии, и начинают активно размножаться.
Важно знать, что наиболее часто заражение у мужчин молочницей происходит тогда, когда у них наблюдается нарушение естественного бактериального баланса. Если человек часто страдает острыми респираторными заболеваниями и проходит курсы лечения антибиотическими препаратами, создаются благоприятные условия для активного размножения грибковых микроорганизмов.
Если заражение произошло давно, но лечебный курс не был доведен до конца, надо помнить, что хроническая форма молочницы не является менее опасной. Существует высокий риск инфицирования последующих половых партнерш и негативных проявлений.
Как мужчина может заразить женщину
Зная ответ на вопрос, может ли мужчина заразиться молочницей от женщины, важно также понимать, какими способами это происходит.
В ряде случаев патология не проявляет себя, и мужчина просто является носителем молочницы, не подозревая об этом. Иногда мужской организм самостоятельно избавляется от проявлений инфекции благодаря сильному иммунитету. Однако мужчины не должны спокойно к этому относиться и ждать, когда кандидоз исчезнет сам — при незащищенном половом акте или оральном сексе он сможет заразить партнершу. Вероятность такого инфицирования достигает 40 процентов. Является ли мужчина переносчиком инфекции, можно определить при помощи специального анализа.
Если грибок проник в женское влагалище, существует шанс, что он не выживет в кислотной среде. Но вредоносный микроорганизм может также прикрепиться к слизистой оболочке в небольшом количестве. Женщины заражаются и в таких случаях становятся также переносчиком. Симптоматика при этом отсутствует. Но если возникнут благоприятные условия, патология может переходить в стадию обострения.
При сильном заражении сразу же развивается острая стадия болезни. Но это случается, когда у женщины есть для этого все предпосылки, например, сниженный иммунитет. Хроническая форма заболевания обостряется с течением времени все чаще, что считается достаточно опасным для организма. Если больной отказывается от лечения, иммунитет постепенно будет ослабевать, и через некоторое время кандидоз распространится на внутренние органы и их системы. В такой ситуации лечение будет производиться уже в комплексном порядке, а при его отсутствии могут возникнуть необратимые осложнения.
При возникновении симптоматики заражения молочницей как женщинам, так и мужчинам следует в кратчайшие сроки обратиться за помощью к специалисту.
Пройдите Онлайн тест и узнаете есть ли у вас молочница. Займет всего пару минут.
Особенность заболевания
Возбудитель кандидоза – грибы Candida, благодаря которым заболевание имеет медицинское название.
Грибы Кандида появляются на кожном покрове, полости рта, во влагалище у женщин, толстом кишечнике у многих здоровых людей. Их количество минимальное, поэтому они не наносят огромного вреда организму. А если их количество активно приумножается, то стоит говорить о факте заболевания.
Чаще всего молочница развивается у женщин. Этому способствует особенность физиологического строения наружных половых органов, в которых всегда влажно и тепло. Более того, организм женщины подвержен всплескам гормонов, которые также вызывают размножение грибка.
Мужская молочница

Мужчина – переносчик молочницы?
Может ли мужчина заразить молочницей женщину? Может, при половом незащищенном контакте. Аналогичным образом мужчина может заразиться от женщины, если у нее влагалищная молочница.
Если женщина вылечилась от молочницы и после повторного полового контакта молочница вновь появилась, то требуется пройти лечение снова. В таком случае лечиться должен и мужчина, принимая системно препараты, даже если симптомов явных нет.
Если же симптоматика проявляется ярко (зуд, жжения, характерные выделения), то при лечении необходимо использовать препараты местного применения – гели, мази, кремы.
Если молочница у мужчины и женщины одновременно, то лечение следует пройти обоим.
Кто виноват?

Женщина может заразиться от мужчины, поскольку грибок не минует и половые органы мужчин. Однако такое явление случается при незащищенном половом акте.
Каким путем передается молочница?
Женщина может заразить мужчину молочницей даже при поцелуе. Однако в том случае, если грибок кандиды активно развивается в полости рта.

Молочница передается при оральных ласках, когда полость рта мужчина имеет прямой контакт со слизистыми половых органов женщины.
Грибы кандиды передают и бытовым путем. К примеру, если пользоваться одним полотенцем, если у женщины обострена влагалищная инфекция. Молочница может перейти даже, если пить с одной чашки и чистить зубы одной щеткой. Однако в том случае, если развивается грибок во рту.

Может ли молочницу мужчина подцепить в бассейне? Урогенитальный кандидоз получить в бассейне мужчине невозможно. Поскольку в качестве дезинфекции используют хлорку, в ней грибок кандиды просто не выживает. Однако в бассейнах часто можно заразиться кандидозом ногтей или околоногтевых валиков.
У женщины молочница может появиться вследствие воздействия обильно хлорированной воды на слизистые оболочки влагалища. Следовательно, при ближайшем половом контакте она заразит мужчину. Случаи заражения молочницей женщин после бассейна редки.
Виды кандидоза
По упрямой статистике, около 10 % мужчин страдали этим заболеванием.
Ранняя стадия протекает бессимптомно, скрыто. В половой сфере мужчин встречаются такие виды молочницы:
- кандидозный цистит – воспаление мочевого пузыря;
- кандидозный уретрит – грибковая инфекция поражает мочеиспускательный канал;
- баланит – состояние, при котором грибок поражает головку мужского члена;
- постит – заболевание, при котором поражается крайняя плоть;
- баланопостит – состояние, в котором поражаются головка полового органа и крайняя плоть одновременно;
- микоз кожи – грибковая инфекция поражает поверхность кожи в паховых складках, между пальцами рук и ног.
В качестве симптомов ощущается сильный зуд и жжение.
Откуда молочница появляется у мужчин?
Мужчина переносит грибковую инфекцию иначе, чем женщины. Однако причины однотипные:
- вследствие длительного лечения антибиотиками;
- при сахарном диабете;
- при дефиците витаминов в организме;
- при избыточном весе;
- при хронических или инфекционных заболеваниях;
- при врожденном фимозе, когда крайняя плоть удлинена и провоцирует скопление и разложение смегмы;
- если у мужчины ВИЧ, СПИД или туберкулез.
Может ли мужчина заразить молочницей женщину? Интимная близость с носителем инфекции приводит к увеличению количества грибов кандида у здорового партнера.

Симптомы начальной стадии
Рассмотрим признаки молочницы у женщин и мужчин. В организмах обоих партнеров происходят такие изменения:
- появляются красные пятна на головке и крайней плоти полового органа/наружной части половых органов;
- к пятнам дополняется творожистый налет;
- пятна увеличиваются в размерах, очаг поражения становится больше;
- налет покрывается пленкой и имеет кислый неприятный запах;
- боль при мочеиспускании и половом акте;
- во время выделения мочи из уретры выделяется жидкость белого цвета, которая внешне напоминает сперму (у женщин обильные вагинальные выделения).
Чаще всего первые признаки у женщин проявляются за семь дней до начала менструации.
Очаг поражения приобретает сильный отек. Жжение и сильный зуд – типичные симптомы молочницы.

Если мужчина обнаружил у себя первые симптомы заболевания, то не следует сразу обвинять партнершу. Необходимо вспомнить, что могло спровоцировать грибковую проблему. Важно, чтобы лечение прошли оба партнера.
Причины
Причины молочницы у женщины и мужчины идентичные. Рассмотрим причины развития кандидоза у мужчин:
- хронические заболевания пищеварительной системы;
- СПИД, туберкулез;
- иммунодефицит;
- алкоголизм, наркомания, табакокурение;
- ожирение;
- неправильное питание, в котором имеется обилие острой, соленой, жареной пищи;
- стресс, депрессия;
- беспорядочная половая жизни;
- сниженный иммунитет;
- сахарный диабет;
- несоблюдение правил личной гигиены.
Мужчина чаще всего заражается кандидозом, если в организме у него наблюдается нарушение бактериального естественного баланса. Если человек часто болеет простудными заболеваниями, употребляет антибиотики, то при таких условиях вполне может развиться молочница.
Как предотвратить развитие молочницы?
Способов заразиться молочницей достаточно много. И через половой и бытовой пути, через бытовые предметы и загрязненные вещи. Только соблюдение мер предосторожности обоими партнерами поможет уберечься от молочницы.
Лечение
Самостоятельно диагностировать у себя молочницу просто невозможно. Необходимо при первом подозрении обратиться к врачу и сдать ряд анализов. Только на основании результатов анализов специалист может поставить диагноз.
Как быстро вылечить молочницу у мужчин? Лечение должно быть направлено на восстановление внутренних сил организма, а не только против грибка. Итак, терапия состоит из приема медикаментов (таблетки и мази), соблюдения диеты и фитотерапии. Следует исключить из рациона шоколадные и кондитерские изделия, копченые продукты, маринад и соленья, а также алкоголь.

Как быстро лечится молочница у женщин? Скорейшему выздоровлению способствует комплексная терапия. Кроме медикаментозного лечения и специальной диеты, нужно соблюдать правила личной гигиены. Синтетическое нижнее белье нужно заменить на натуральное.
Последствия
Молочница – опасное заболевание тем, что при несвоевременном лечении или отсутствии профилактических мер может появиться проблема с детородной функцией.
Если мужчина вовремя не начал лечиться, то у него может развиться импотенция. Для женщин наплевательское отношение к лечению может привести к бесплодию и возникновению заболеваний половых органов, а именно:
- воспаление яичников;
- эрозия шейки матки;
- изменение формы влагалища.
Для мужчин характерны такие последствия заболевания:
Мужчины могут заразить свою вторую половинку молочницей.
Самолечением заниматься не стоит, поскольку бесконтрольный прием медикаментов спровоцирует ослабление иммунитета и может вызвать ряд осложнений. Самое верное решение – пойти к врачу для обследования. Только при квалифицированной помощи можно позабыть о проблеме раз и навсегда.
Заразна ли молочница?
Мужчины в меньшей степени подвержены риску развития болезни. Может ли мужчина заразиться молочницей от женщины — это довольно актуальная тема. Патология заразна и может передаться, как от женщины представителю сильной половины общества, так и наоборот. Причем интимный контакт — далеко не единственный способ инфицирования. Заражение может произойти и бытовым путем, при использовании партнерами общих предметов гигиены.

Болезненность заболевания у мужчин может быть неинтенсивной. Однако, после инфицирования, молочница и может проявить некую симптоматику, которая характерна для мужчин, а может исчезнуть и в течение часа без видимых последствий.
При появлении первой тревожной симптоматики необходимо в незамедлительном порядке обратиться за помощью квалифицированного специалиста. Игнорирование проявлений заболевания чревато переходом болезни в хроническую форму, что более опасно для здоровья, так как увеличивается риск развития серьезных осложнений.
В норме грибы рода Кандида должны присутствовать в организме. Эти микроорганизмы относятся к условно-патогенным микроорганизмам. Среда обитания грибка — рот, слизистые половых органов, кожа.
Грибы приносят организму пользу, они принимают активное участие в синтезе витаминов. Но если по каким-то причинам отмечается возрастание численности микроорганизмов, то есть развивается дисбаланс микрофлоры, появляется симптоматика кандидоза.
Заразна ли молочница? Этот вопрос задает абсолютно каждый человек, который столкнулся с недугом. Патология заразна. Она может развиваться не только у женщин, как принято полагать, но и мужчин и даже ребенка.
Заражение может происходить несколькими способами, самым распространенным является интимная близость.
Почему кандидоз у взрослых людей чаще всего локализуется в половых органах? Женское влагалище изобилует кожными складками и имеет влажную и теплую слизистую оболочку – это идеальная среда для развития кандид, тем более что тщательно очистить влагалище после полового акта без спецсредств не представляется возможным.
Так что кандидозом болеют в основном женщины, что касается мужского полового органа, то его строение таково, что половой контакт с кандидоносителем не всегда заканчивается инфицированием. Дело в том, что кандиды просто не успевают укрепиться на слизистой головки полового члена. Скорее всего, они удержатся в складках крайней плоти и начнут там размножаться.
Именно поэтому для мужчины так важно соблюдать интимную гигиену – даже если произошел контакт с кандидоносителем, мужчине достаточно тщательно вымыться, очистив от слизистой все складки крайней плоти. Также стоит очистить уретру – для этого стоит опорожнить мочевой пузырь вскоре после полового акта. Такие несложные манипуляции не позволят грибкам задержаться на теле мужчины.


Как вариант, кандиды могут находиться в слизистой мужчины, но не проявлять себя – размножение грибка сдерживает иммунная защита человека. На фоне падения иммунитета кандиды, оказавшись в благоприятных для себя условиях, начинают активно размножаться, что обусловливает появление характерных симптомов:
- Жжение;
- Зуд;
- Покраснение;
- Нехарактерные творожистые выделения;
- Болевые ощущения при мочеиспускании;
- Боль при половом акте.
Причиной молочницы являются условно-патогенные грибы рода Candida, в минимальных количествах присутствующие на слизистых оболочках у здорового человека. Заболевание развивается при активном размножении возбудителей, которое наблюдается при ослаблении иммунитета и воздействии на организм внешних и внутренних факторов. К внешним причинам, ослабляющим реактивную способность организма, относятся:
- перегрев или переохлаждение;
- длительное нахождение под солнцем;
- стрессы;
- нерациональное питание с большим содержанием простых углеводов;
- несоблюдение интимной гигиены;
- ношение синтетического белья;
- большое количество половых партнеров.
Так как дрожжеподобные грибы являются условно-патогенными микроорганизмами, то при возникновении или обострении болезней создаются условия для благоприятного размножения кандиды. Например, простуда может спровоцировать появление молочницы.
Грибок является одной из самых актуальных проблем современного общества, несмотря на век инновационных разработок, и высоких технологий. Как показала практика, практически каждая женщина сталкивается с грибковыми половыми инфекциями, а по всей планете от грибка ежегодно страдает около 40% населения.
Слизистая оболочка очень восприимчива к патогенным организмам. Попав в рот со слюной, к примеру, после поцелуя, грибки начинают активно развиваться. Табачный дым негативно сказывается на микрофлоре ротовой полости. Полезные микроорганизмы погибают, и их место занимают патогенные.
Заболевание вызывают грибы рода Candida tropicаlis и аlbicаns. Эти формы и диагностируются в большинстве случаев у пациентов. Мужчина, заразившись от женщины половым путем, не всегда ощущает симптомы. Порой заболевание может не выявлять себя ничем. Мужчина же при этом является скрытым носителем. Именно по этой причине столь важно проводить лечение одновременно двум половым партнерам, чтобы кандидоз не проявил себя вновь.
Совместное проживание с женщиной, у которой прогрессирует молочница, мужчине может грозить заражением. Помимо этого, при незащищенном оральном сексе риск заражения увеличивается многократно. У женщины во рту присутствует большое количество дрожжевых грибков. Со слюной они попадают на член полового партнера и начинают там размножаться.
Так как молочница часто поражает половые органы, то на фоне инфекции половая жизнь становиться невозможной, причиняет дискомфорт и боль. Важно знать, заразна ли молочница и стоит ли лечить полового партнера при её проявлениях.
Молочница — это воспаление слизистых и кожи, вызванное грибком рода кандида. У женщин поражается влагалище и вульва — вульвовагинальный кандидоз. У мужчин молочница поражает головку полового члена и крайнюю плоть – кандидозный баланопостит.
Количество дрожжевых грибков в организме увеличивается по разным причинам. Одна из них связана с иммунитетом. При ослаблении иммунитета грибки начинают активнее размножаться. Кроме этого, не стоит забывать и про элементарную гигиену и половые связи. При беспорядочном ведении этих процедур велика вероятность появления проблем с членом.
Пути заражения молочницей
Бытует мнение, что передать молочницу своему партнеру женщина может исключительно во время полового акта. В большинстве случаев это действительно так, однако возможны и другие пути передачи возбудителя.
Как правило, главными источниками заболевания кандидоза считается употребление антибиотиков, гормональный сбой, нарушение правил личной гигиены, неправильное питание и т.д. Подобные трудности вполне подходят как для женщин, так и для мужчин. Отсюда следует, что и заболевание может подхватить каждый.
Риск заражения повышается при наличии сахарного диабета, а также при неправильном питании и тяжелой работе. Возбудитель инфекции устойчив к негативным факторам окружающей среды, поэтому нередко он присутствует не только в составе микрофлоры, но и на поверхности бытовых предметов. Молочница может передаваться следующими путями:
- инфицирование половым путем. Как правило, оно происходит во время незащищенного полового акта. Если в микрофлоре влагалища женщины присутствуют болезнетворные бактерии, то они попадут в мужской организм. При этом партнер может даже не подозревать об этом, пока по каким-либо причинам иммунитет не даст сбой. Все это время мужчина является переносчиком недуга;
- через поцелуй. Если в ротовой полости у женщины есть грибок, то вместе со слюной он может передаться мужчине;
- через оральные ласки. Бактерии, живущие на слизистой во рту у девушки, попадают в мужской организм во время орального секса.
Существует и такое понятие, как супружеская молочница, при которой грибок развивается в микрофлоре половых органов у обоих партнеров, состоящих в браке. Инфицирование происходит во время интимной близости.
В частности, огромное количество бактерий содержится в слюне, и молочница вполне может передаться вместе с банальными поцелуями. Кроме того, мужчина может быть зараженным и бытовым путем, через предметы, которых касался зараженный человек.
Однако в том случае, если у одного партнера была выявлена молочница, а другой совершенно не жалуется на ее проявления, отправляться в больницу нужно обоим для того, чтобы с молочницей можно было бы распрощаться навсегда. Даже если на первый взгляд кажется, что заразилась только женщина, мужчина должен переступить через свою гордость и сдать анализы вместе с ней. Как показывает практика, примерно в 99% случаев возбудитель молочницы присутствует у обоих партнеров.
Кроме того, почувствовав недомогание, ни в коем случае не стоит заниматься самолечением, которое может очень дорого обойтись.
Ослабленный бесконтрольным приемом медицинских препаратов организм станет более восприимчивым к огромному множеству инфекций, среди которых наверняка найдется и молочница!
Многие люди задаются вопросом: передается ли молочница бытовым путем? Заражение этим способом происходит не так часто, но подобные случаи также распространены. Способы заражения через бытовые предметы возможны в том случае, если на одной территории проживает здоровый и больной человек. При общем использовании мыла, губки, бритвенных станков и даже полотенец инфекция способна попасть в здоровый организм.
Как девушки, так и мужчины могут передать или получить заболевание через бытовые предметы. На бритвенных станках или мыле грибки развиваются довольно длительное время. В основном от заражения инфекцией чаще всего страдают женщины, так как их иммунитет менее устойчив к воздействию недуга.
Многие считают, что заразиться молочницей половым путем мужчина не может. Однако это далеко не так. Кандидоз поражает организм мужчины изнутри. Внешние проявления заболевания являются лишь симптомами развития заболевания. По этой причине, половой путь является способом передачи возбудителя от носителя к здоровому человеку.

Кандидоз не способен развиваться в мужском организме также, как в женском. Это легко объясняется с физиологической точки зрения. Строение половых органов мужчины не способствует закреплению и размножению дрожжевых грибков непосредственно на поверхности головки. Поражение грибками переходит на мочеиспускательный канал. Однако и там грибкам тяжело размножаться, так как мужской организм имеет стабильный гормональный фон и, в большинстве случаев, сильный иммунитет.
У мужчин кандидоз очень часто поражает слизистую ротовой полости. Грибки передаются через поцелуй с женщиной больной молочницей. Также заболевание развивается благодаря таким пагубным привычкам, как курение. Вредные вещества, находящиеся в табачном дыму, негативно влияют на микрофлору ротовой полости.
Ряд специалистов утверждает, что обычный поцелуй не может стать причиной заражения. Однако исследования показали, что кандидоз с легкостью может передаваться через слюну. Проникая в ротовую полость, дрожжевые грибки создают дисбаланс в микрофлоре. Здоровый организм с трудом справляется с этим. Если же у человека по каким-либо причинам снижен иммунитет, то молочница начинает активно развиваться.
Еще один способ передачи кандидоза – половой. Мужчины весьма восприимчивы к раздражающим факторам. При незащищенном сексе грибки попадают на головку полового члена, вызывая аллергические реакции. Молочница при этом может не развиваться, однако мужчина становится скрытым носителем этого заболевания и способен передать своему половому партнеру заболевание. Передаться заболевание от женщины мужчине может через слюну во время поцелуя или незащищенного орального секса.

Также заражение может произойти бытовым способом при использовании на двоих одних средств гигиены: полотенца, зубной щетки. Посуда также является средством для передачи кандидоза. При наличии молочницы на слизистой поверхности в ротовой полости, грибки могут попадать на поверхность посуды. Если она не пройдет достаточной термической обработки, то человек, который будет принимать пищу с нее, может заразиться.
Некоторых волнует вопрос, молочница передается при посещении бассейна или нет? В силу того, что воду в бассейне дезинфицируют хлоркой, это практически невозможно. В бассейне можно заболеть кандидозом ногтей.
Помимо способов заражения молочницей, имеется множество причин, которые повышают риск инфицирования.
- Терапия антибиотиками
- Терапия гормональными медикаментами
- Авитаминоз
- Нарушение метаболизма
- Заболевания щитовидной железы у мужчн
- Нарушение работы желудочно-кишечного тракта
- Снижение иммунитета
- Инфицирование герпесом
- Врожденная форма фимоза у мужчин.
Профилактика молочницы у мужчин
Так как молочница для мужчин заразна, то лучшим способом обезопасить себя от болезни является использование презервативов.
Для профилактики и предупреждения мужской молочницы:
Лечение молочницы
Лечение кандидоза у мужчин должно быть постепенным. Изначально необходимо сдать посев на флору, с целью определения чуткости к противогрибковым средствам. По результатам назначается эффективная противогрибковая терапия.
Кроме этого, необходимо исключить источники, которые спровоцировали интенсивное развитие грибков Кандида:
- Если это возможно, исключить употребление антибиотиков;
- Наладить метаболизм;
- Активизировать иммунитет;
- Наладить естественную микрофлору пениса (назначают бактериальные средства, в состав которых входят живые культуры лактобактерий, блокирующие развитие грибов и патогенной микрофлоры);
- Ликвидировать дисбактериоз кишечника.
Избавление от тревожащих симптомов не всегда свидетельствует о полном излечении молочницы. По этой причине после прохождения лечения, следует повторно показаться врачу. Терапию от заболевания рекомендуется проходить обоим партнерам.
Как защититься от молочницы?
Чтобы предотвратить инфицирование необходимо помнить не только, как передается молочница от женщины мужчине и наоборот, но и основные методики профилактики. И хотя стопроцентной методики защиты от кандидоза нет, следует соблюдать несколько основных правил:
- Направьте максимум усилий на поддержание иммунитета на должном уровне. Займитесь спортом, откажитесь от вредных привычек, правильно питайтесь и больше времени проводите на свежем воздухе.
- Специалисты утвердительно отвечают на вопрос, передается ли молочница мужчинам от женщин. Поэтому для представителей сильного пола самым действенным способом защититься от болезни станет использование презервативов во время сексуальных контактов. От беспорядочных связей с непроверенными партнершами лучше вовсе отказаться.
- Молочница передается партнеру во время секса, поэтому сразу же после окончания полового акта необходимо проводить тщательный туалет половых органов. Для этого разрешено использовать антисептические препараты, например, Хлоргексидин или Мирамистин. Предотвратить молочницу при активной половой жизни помогут и подмывания с применением раствора марганцовки.
- Мужчинам и женщинам для защиты от молочницы необходимо пересмотреть свой рацион питания. Из него придется удалить мучные изделия, сладости, копчености, жирные и жареные блюда. В меню должно быть как можно больше овощей и фруктов. Каждый день выпивайте не менее двух стаканов кисломолочных напитков.
- После принятия душа необходимо насухо вытирать кожу половых органов. Для этого лучше использоваться мягкое махровое полотенце. Если супруг заразился молочницей, то у жены и остальных членов семье обязательно должны быть отдельные предметы личной гигиены.
- Никогда не оставайтесь надолго в мокром купальнике или плавках. В условиях высокой температуры и достаточной влажности грибок начинает быстро размножаться.
- Спать лучше всего без одежды. Это позволит коже спокойно дышать и не потеть.
Всегда необходимо помнить, что ответ на вопрос, может ли молочница передаваться половым и бытовым путями, утвердительный. Поэтому необходимо строго соблюдать все правила профилактики и внимательно относиться к своему здоровью.
Кандидоз заразен для женщин, мужчин и детей. Заразившись один раз, велика вероятность многократных рецидивов. Поэтому при первых неприятных симптомах необходимо обращаться к врачу и проходить обследование. Только специалист сможет подобрать грамотную методику терапии, которая быстро принесет положительный результат.
Читайте также:









